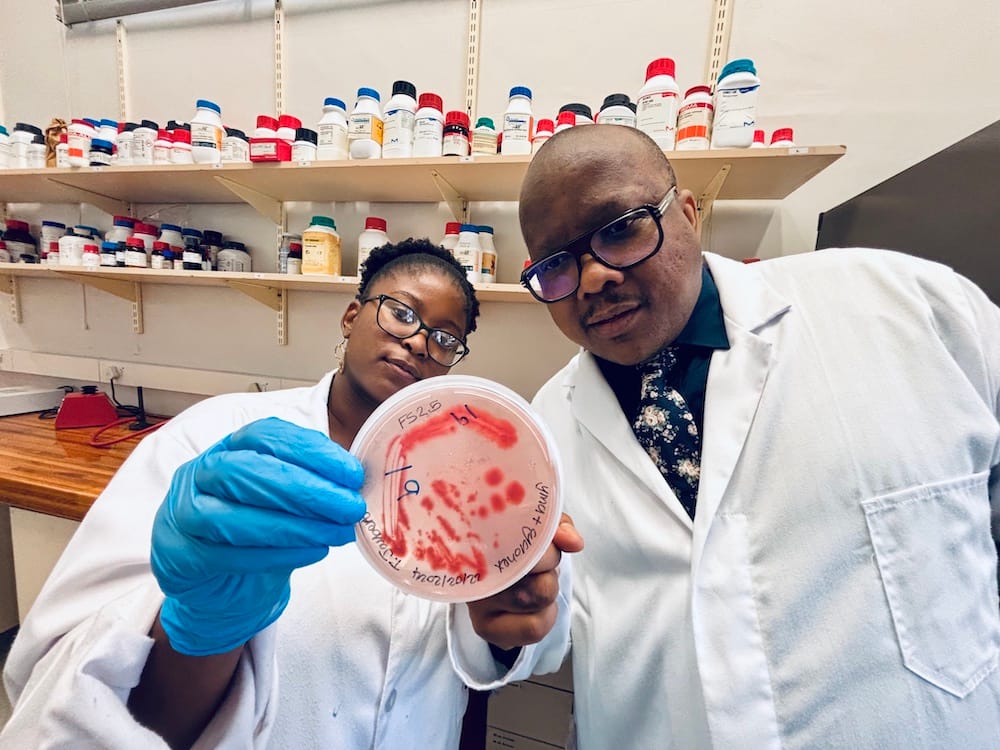
Dr. Itumeleng Moroenyane and a female student researcher in white lab coats examine a petri dish containing pink/red bacterial or fungal colonies in their microbiology laboratory. The student, wearing blue nitrile gloves, holds up the culture plate while both scientists smile at the camera. Behind them, wooden shelves are lined with numerous laboratory reagent bottles with colorful caps, typical of a well-equipped research lab.

Plants are incredibly diverse, and so are botanists! In its mission to spread fascinating stories about the plant world, Botany One also introduces you to the scientists behind these great stories.
Today, we have Dr. Itumeleng Moroenyane, a passionate plant holobiont scientist and Senior Lecturer at Stellenbosch University in South Africa. His research dives into the fascinating relationships between plants and their friendly microbial communities, known as the holobiont. Moroenyane explores how these interactions influence plant health, stress tolerance, and adaptation, especially in the face of climate change. In a fun twist, he likes to think of it as studying the gossip within the rhizosphere; who’s chatting?, what’s being shared?, and whether it’s friendly or a bit suspicious. Feel free to check out his work at his lab’s website or connect with him on Twitter/X at @Itumeleng_M . In his own words, Moroenyane aims to “keep it grounded in science while adding a sprinkle of fun(gi)!”.

What made you become interested in plants?
Plants are the quiet achievers of our beautiful biosphere! They graciously feed us, clothe us, and even provide the oxygen our busy brains crave, yet they often go unappreciated. I was first captivated by plants because of their elegant problem-solving abilities. As my fascination deepened, I realised that they don’t operate in isolation; instead, they play vital roles in complex ecological symphonies, mostly involving tiny microbes! Once I discovered that the real magic occurs invisibly around their roots, stems, and seeds, I was completely hooked. Plants don’t just endure; they truly collaborate. And honestly, who wouldn’t want to dive into the study of such cooperative brilliance beautifully disguised as lush green stillness?
What motivated you to pursue your current area of research?
When I discovered that a plant is never truly alone – its immune responses, nutrient uptake, and stress tolerance all depend on the support of microbial co-pilots – it completely transformed my perspective on biology! The idea of holobiont thinking, which emphasises that individual organisms are really ecological collectives, was particularly inspiring. It’s like realising that your favourite solo artist is actually part of a legendary band. My research is fueled by a desire to understand how this ‘band’ plays together under stress, whether it’s drought, heat, or pests, and how we can create new agricultural and ecological harmonies in our changing climate.
What is your favourite part of your work related to plants?
I truly appreciate the constant reminder that things are often more complex than they appear. A wilting leaf? It could be due to drought, but maybe the plant’s little microbial friends are on strike or even unionised! What I absolutely love is exploring the exciting crossroads of molecular ecology, plant physiology, and microbiome science. It’s all about asking those big questions about resilience and communication, followed by getting my hands dirty in the soil to uncover the answers; quite literally! Plus, I absolutely cherish the moments spent mentoring young scientists. Their eyes light up when they discover that plants might be sharing their secrets with microbes, and microbes could be communicating back, too.
Are there any specific plants or species that have intrigued or inspired your research?
Soybean is truly a star in my lab! It’s humble yet incredibly high-performing, and its excellent symbiotic relationships with rhizobia and other microbes make it such an exciting model for holobiont research. I’m also captivated by South Africa’s Sutherlandia frutescens; it’s a remarkable medicinal plant with deep connections to local traditional indigenous knowledge systems (IKS), and it probably harbours an equally fascinating microbial entourage. Both of these systems provide such amazing opportunities to explore big questions about plant-microbe communication, drought resilience, and the role of microbial volatiles. And honestly, if soybeans had a group chat, I’d absolutely want to be a part of it!
Could you share an experience or anecdote from your work that has marked your career and reaffirmed your fascination with plants?
While working in the field with drought-stressed soybeans, a student playfully suggested we should “sprinkle probiotics” on the roots like yoghurt on cereal. I chuckled at first… but then took a moment to think. Surprisingly, the idea was quite close to reality! That summer, our team successfully isolated microbial strains that enhanced water-use efficiency in soybeans even in harsh heat and drought conditions. Witnessing the plants thrive, standing taller and blooming beautifully, thanks to the microbial treatments we applied, was truly inspiring. It reminded me that holobiont research is not just a concept. It’s tangible, impactful, and grounded in real-world solutions.
What advice would you give young scientists considering a career in plant biology?
Keep that curiosity alive, dive into different fields, and always remember that the plants often have more wisdom to share than we do! Don’t hesitate to explore the fascinating world of microbes, and they could lead you to wonderful insights about your plant system. Also, it’s important not to get too attached to just a few model organisms. The real world is wonderfully complex and filled with plants that aren’t bound by Arabidopsis protocols. So, embrace that beauty! And don’t forget to invest in some good sunscreen, you might find yourself spending more time outdoors than you initially thought!
What do people usually get wrong about plants?
Many think of plants as passive, but they are actually strategic, social, and sometimes quite clever (in the most wonderful biological way). They sense their surroundings, respond thoughtfully, remember important details, and even recruit microbial bodyguards to help them out. Instead of seeing them as mere background characters in ecosystems, we should recognise them as the executive producers of their environments. It’s a common misconception to assume they act alone. Holobiont thinking changes that perspective: a plant is never just a plant. It’s a vibrant ecosystem, a rich archive of interactions, and a skilled diplomat negotiating with bacteria, fungi, insects, and the atmosphere around it. In summary, plants are not just wallflowers; they are truly excellent networkers!


Carlos A. Ordóñez-Parra
Carlos (he/him) is a Colombian seed ecologist currently doing his PhD at Universidade Federal de Minas Gerais (Belo Horizonte, Brazil) and working as a Science Editor at Botany One and a Communications Officer at the International Society for Seed Science. You can follow him on BlueSky at @caordonezparra.
